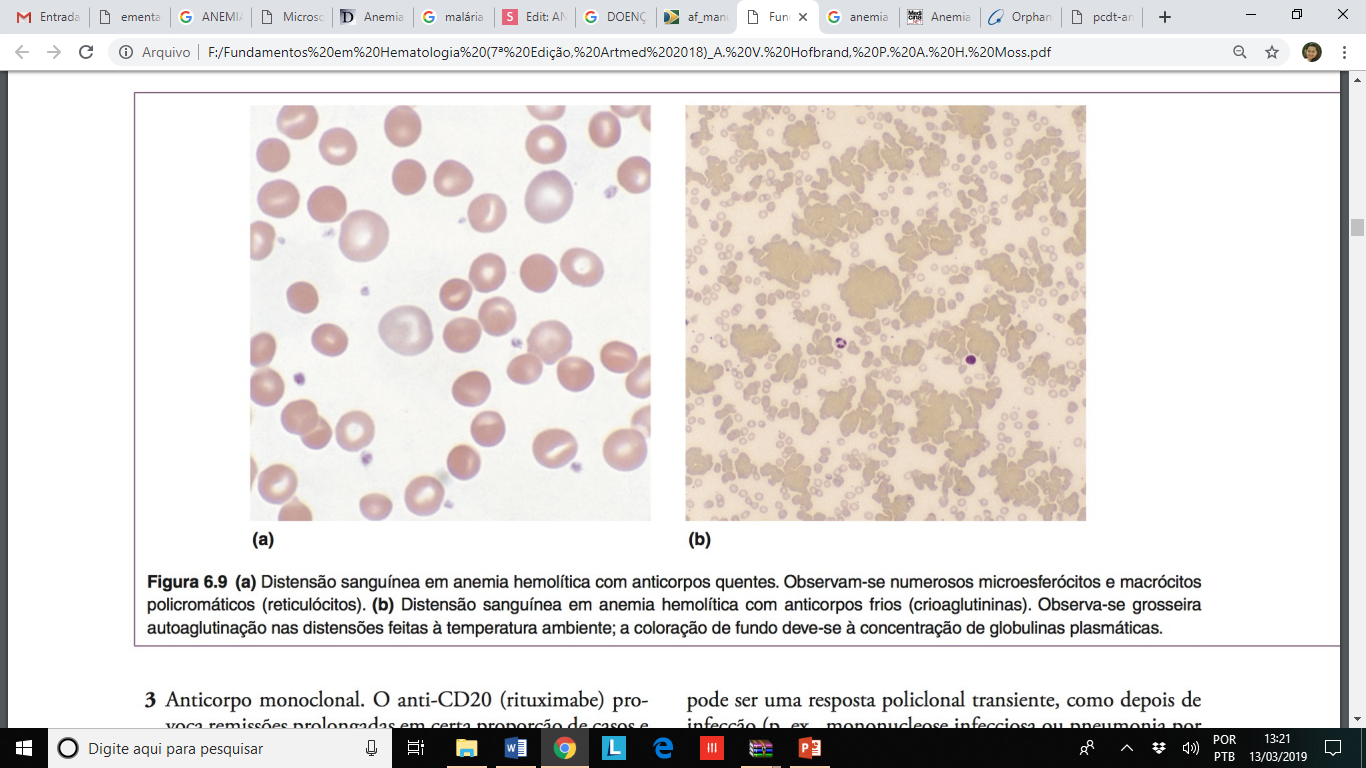

ANEMIAS POR DESTRUIÇÃO PERIFÉRICA AOS ERITRÓCITOS
A hemólise pode ocorrer por dois mecanismos: intravascular e extravascular.
A hemólise intravascular corresponde à destruição dos eritrócitos na corrente sanguínea, havendo libertação do conteúdo eritrocitário para o plasma.
A hemólise extravascular é a forma mais comum de hemólise e é caracterizada pela remoção e destruição dos eritrócitos com alterações da membrana pelos macrófagos do Sistema Reticuloendotelial.

ANEMIAS POR DESTRUIÇÃO PERIFÉRICA AOS ERITRÓCITOS
HEMOPARASITOSE
ANEMIAS POR DESTRUIÇÃO PERIFÉRICA AOS ERITRÓCITOS
A Malária destaca-se como uma parasitose de fase aguda ou crônica causada por protozoários do gênero Plasmodium, transmitidos pela picada do mosquito Anopheles


A anemia hemolítica autoimune (AHAIs) são causadas pela produção de anticorpos contra eritrócitos do próprio corpo.
São caracterizadas por teste direto de antiglobulina (DAT ou teste de Coombs) positivo.
São divididas em dois tipos: "quente" e "frio", dependendo da temperatura ótima com que os anticorpos reagem mais fortemente com os eritrócitos (37ºC ou 4º a 18ºC)
Na AHAI a quente, os autoanticorpos “quentes” reagem mais fortemente à temperatura corporal (37° C), sendo incapazes de aglutinar as hemácias, e a hemólise ocorre pela destruição pelo sistema reticuloendotelial.
Na AHAI a frio, os autoanticorpos “frios” se ligam aos eritrócitos em temperaturas entre 4º-18° C, podendo levar à aglutinação de eritrócitos na circulação sanguínea, e, ao ser ativado o sistema complemento, ocorre a hemólise.
A AHAI também pode ser classificada com base em sua etiologia.
A AHAI idiopática ou primária não apresenta correlação com a doença de base, já a secundária está associada a doenças linfoproliferativas, imunodeficiências, uso de medicamentos ou neoplasias.
ANEMIA HEMOLÍTICA AUTOIMUNE POR ANTICORPOS "QUENTES"
Os anticorpos que reagem à temperatura corporal são quase sempre IgG, raramente IgM ou IgA.
AHAI a quente é classificada como secundária em cerca de 25% dos casos. Neoplasias linfoides e doenças do colágeno, como lúpus eritematoso sistêmico, artrite reumatóide e imunodeficiências, são as doenças mais frequentemente associadas. Medicamentos tais como cefalosporinas, levodopa, metildopa, penicilinas, quinidina e anti-inflamatórios não esteroidais também são classicamente descritos como causadores de AHAI a quente.
ANEMIA HEMOLÍTICA AUTOIMUNE POR ANTICORPOS "FRIOS"
Os anticorpos ativos em baixas temperaturas causam duas doenças clinicamente distintas: a doença das aglutininas a frio (crioaglutininas) e a hemoglobinúria paroxística a frio.
A doença das aglutininas a frio é mediada por anticorpo IgM contra antígenos polissacarídeos na superfície das hemácias em 90% dos casos. Os anticorpos “frios” são usualmente produzidos em resposta a infecções ou por doenças linfoproliferativas.
A forma mais comum, no entanto, é a idiopática ou primária, que ocorre principalmente em indivíduos na sexta e sétima décadas de vida.
ANEMIA HEMOLÍTICA AUTOIMUNE POR ANTICORPOS "FRIOS"
Hemoglobinúria paroxística a frio é um subtipo raro de AHAI descrita inicialmente como manifestação de sífilis terciária.
A patogênese resulta da formação do anticorpo policlonal de Donath-Landsteiner, um anticorpo IgG direcionado ao antígeno P da superfície da membrana eritrocitária.
As crises são precipitadas quando há exposição ao frio.
ANEMIA HEMOLÍTICA AUTOIMUNE
DIAGNÓSTICOS LABORATORIAL
Hemograma: deve evidenciar anemia caracterizada por hemoglobina abaixo de 13 g/dL em homens e abaixo de 12 g/dL em mulheres.
Teste de Coombs direto: deve ser positivo, caracterizando anticorpos ligados à superfície das hemácias.
Teste para comprovação de hemólise: caracteriza-se por aumento de reticulócitos e desidrogenase láctica (DHL). A bilirrubina indireta pode estar elevada nos pacientes com hemólise grave.


CASO CLÍNICO
Identificação: Mulher, 48 anos, professora primária, natural de Batatais, residente em Ribeirão Preto.
Queixa: Há três semanas começou apresentar cansaço e fraqueza, que vêm se acentuando desde então. Logo que esses sintomas começaram, seus familiares perceberam que estava muito “branca”, e ela notou que o “branco dos olhos” estava amarelo. Procurou então um médico que disse que provavelmente tratava-se de “hepatite”. Pediu para realizar alguns exames e receitou-lhe repouso. Há dez dias retornou ao médico que, observando os resultados dos exames, disse-lhe que ela estava com “anemia” e receitou duas transfusões de sangue. A paciente diz que obteve ligeira melhora com as transfusões, mas que dois dias depois estava novamente muito fraca. Uma nova transfusão realizada há cinco dias não teve qualquer efeito. A paciente acha, ainda, que a cor amarela dos olhos aumentou nos últimos dez dias. A paciente nega febre, calafrios, perda de peso, sudorese excessiva ou dores.




ANEMIA POR FRAGMENTAÇÃO DOS ERITRÓCITOS
Síndromes de fragmentação são desencadeadas quando há danos físicos aos eritrócitos, em superfícies anormais.
Exemplos de superfícies anormais: válvulas cardíacas artificiais ou enxertos arteriais, má formação arteriovenosa.
Este tipo de anemia é causada pela passagem de eritrócitos através de pequenos vasos anormais.

*Esquizócito: eritrócitos com formas distorcidas em virtude da fragmentação.
HEMATOLOGIA CLÍNICA - ANEMIAS POR DESTRUIÇÃO PERIFÉRICA DOS ERITRÓCITOS
By KELLY EMI HIRAI
HEMATOLOGIA CLÍNICA - ANEMIAS POR DESTRUIÇÃO PERIFÉRICA DOS ERITRÓCITOS
- 1,608